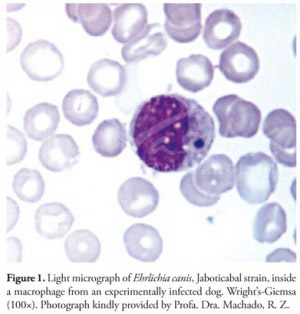
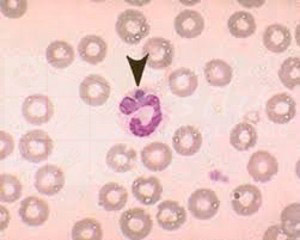
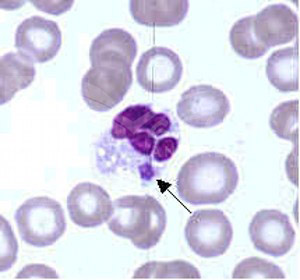

Από την υπεύθυνη Κτηνίατρο και ιδιοκτήτρια, Βασιλική Α.Νταβλούρου. BVM, GPCert(ExAP),MRCVS.- Αρχικό κείμενο 2014. Αναθεωρημένο κείμενο 2016.
Σε αυτό το άρθρο θα βρείτε πληροφορίες σχετικά με την ασθένεια της Ερλιχίωσης στο σκύλο.
Θα ήθελα να τονίσω ότι όπως όλα τα άρθρα αυτής της ιστοσελίδας, έτσι και το συγκεκριμένο, έχουν ως μόνο σκοπό την ενημέρωση ανθρώπων που ασχολούνται με κτηνιατρικά θέματα. Είτε είναι οι ίδιοι ιδιοκτήτες κατοικιδίων ζώων είτε όχι. Δεν πρόκειται για επιστημονικά άρθρα που απευθύνονται μόνον σε ειδικούς του κλάδου, γι'αυτό και η γλώσσα που χρησιμοποιώ είναι όσο το δυνατό πιο απλουστευμένη προκειμένου να γίνεται κατανοητή. Αυτό βέβαια δεν σημαίνει πως όσα αναφέρονται, δεν είναι επιστημονικά τεκμηριωμένα. Για κάθε άρθρο που δημοσιεύω σε αυτή την ιστοσελίδα γίνεται πολύωρη προετοιμασία-μελέτη και χρησιμοποιούνται πολλές έγκυρες επιστημονικές πηγές, σε συνδυασμό με την προσωπική μου γνώση και εμπειρία όλων των χρόνων ενασχόλησής μου με την κτηνιατρική επιστήμη. Στο τέλος κάθε άρθρου αναφέρονται οι πηγές από τις οποίες δανείστηκα τη γνώση για να σας τη μεταφέρω.
ΕΡΛΙΧΙΩΣΗ λοιπόν,
ή αλλιώς,
Η ασθένεια από το ΤΣΙΜΠΟΥΡΙ!
Η Ερλιχίωση του σκύλου είναι δυστυχώς και αυτή (όπως και η Λεϊσμανίωση-Kαλα αζάρ) μια πολύ διαδεδομένη ασθένεια, που μπορεί να οδηγήσει ένα ζώο στο θάνατο, όταν η διάγνωσή της δεν γίνει έγκαιρα.
Οι ιδιοκτήτες σκύλων που ζουν στην Ελλάδα ή επισκέπτονται τη χώρα μας καθώς και χώρες όπου η νόσος ενδημεί (εμφανίζεται συχνά και με διάρκεια), θα πρέπει να ενημερώνονται σχετικά με τους κινδύνους μετάδοσης της ασθένειας αυτής στα ζώα τους και να τους δίνονται οι απαραίτητες συμβουλές και οδηγίες προκειμένου να αναζητούν έγκαιρα τη βοήθεια Κτηνιάτρου!
Η προσωπική μου άποψη είναι πως η ασθένεια αυτή ενώ στην αντιμετώπισή της είναι πολύ πιο απλή από την Λεϊσμανίωση και η πλήρης ίαση του ζώου αρκετά πιο εφικτή, μπορεί να αποδειχθεί πολύ πιο επικίνδυνη εξαιτίας κυρίως της ελλειπούς ενημέρωσης των ιδιοκτητών σκύλων σχετικά με τους κινδύνους από την "απλή" παρουσία τσιμπουριών πάνω στο ζώο τους. Αλλά και την ίδια την ασθένεια, προσωπικά θα την χαρακτήριζα πιο "σιωπηλή" και "ύπουλη" σε σχέση με την Λεϊσμανίωση.
Αυτό που εννοώ είναι πως οι περισσότεροι ιδιοκτήτες σκύλων πλέον γνωρίζουν τη Σκνίπα και τη Λεϊσμανίωση, ενώ αγνοούν τους κινδύνους που απορρέουν από ένα "απλό" τσίμπημα από τσιμπούρι!
Μία επίσης ενδιαφέρουσα κατά τη γνώμη μου παρατήρηση είναι πως ενώ και οι δύο είναι ασθένειες του "αίματος" του σκύλου, η Λεϊσμανίωση στην πλειοψηφία των περιστατικών εκδηλώνεται με την δερματική της μορφή την οποία οι περισσότεροι ιδιοκτήτες σκύλων σήμερα είναι σε θέση να αναγνωρίσουν έγκαιρα! Η Ερλιχίωση όμως, δεν προκαλεί χαρακτηριστικές εξωτερικές αλλαγές στο ζώο παρά μόνον σε προχωρημένα στάδια όπου μπορεί να εμφανιστούν διάσπαρτες αιμορραγικές αλλοιώσεις στο σώμα του ζώου με τη μορφή "πετεχειών" ή "εκχυμώσεων". Ως αποτέλεσμα, όταν ο ιδιοκτήτης αντιληφθεί αυτές τις αλλοιώσεις πάνω στο σώμα του ζώου του, η νόσος να έχει ήδη προχωρήσει.

(Διάσπαρτες πετέχειες στο δέρμα ενός σκύλου που νοσούσε από χρόνια Ερλιχίωση. Φωτο. από το αρχείο του ιατρείου)
Η απουσία λοιπόν χαρακτηριστικών εξωτερικών αλλαγών στο σώμα του ζώου από τη νόσο της Ερλιχίωσης, μαζί με την ποικίλλη κλινική της εικόνα, ευθύνονται κυρίως για την συχνά καθυστερημένη διάγνωσή της και τότε δυσμενή πρόγνωσή της.
♦Είναι αλήθεια πως ένας τεράστιος αριθμός σκύλων στην χώρα μας υποφέρει από τη Λεϊσμανίωση (Καλα-αζάρ). Ένας επίσης μεγάλος αριθμός όμως, διαγιγνώσκεται καθημερινά αλλά και πεθαίνει από τη νόσο της Ερλιχίωσης.
♦Οι περισσότεροι τώρα πια ιδιοκτήτες σκύλων είναι ενημερωμένοι σχετικά με την ανάγκη προληπτικών εξετάσεων αίματος κάθε χειμώνα για τη Λεϊσμανίωση.
Η εμπειρία μου όμως μετά από 7 χρόνια εξάσκησης της Κτηνιατρικής στην Ελλάδα μου επιτρέπει να συμβουλεύσω πως στον ετήσιο αιματολογικό έλεγχο ενός σκύλου που είτε ζει είτε έχει ταξιδεύσει σε ενδημικές περιοχές (περιοχές όπου συναντάται συχνά η νόσος), θα πρέπει να προστεθεί και η εξέταση της Ερλιχίωσης (και άλλων ασθενειών μεταδιδόμενων από τσιμπούρια!!!) ή τουλάχιστον μιας ΓΕΝΙΚΗΣ αιματολογικής εξέτασης που δίνει πολύτιμες πληροφορίες οι οποίες όπως θα εξηγήσω παρακάτω θα μπορούσαν να οδηγήσουν στην έγκαιρη διάγνωση της Ερλιχίωσης (ή άλλης παρόμοιας μεταδιδόμενης από τσιμπούρι ασθένειας). Στο συμπέρασμα αυτό κατέληξα μετά από τη διάγνωση της Ερλιχίωσης σε ένα μεγάλο αριθμό ζώων, στα περισσότερα από τα οποία το μόνο που ανέφεραν οι ιδιοκτήτες τους στο ιστορικό ήταν μια "μικρή" αδιαθεσία, μικρής διάρκειας "ανορεξία" (την οποία να σημειωθεί πως οι περισσότεροι ιδιοκτήτες απέδιδαν στην Καλοκαιρινή ζέστη) και γενικά ατονία του ζώου που σε καμία περίπτωση δεν θα παρέπεμπε σε κάτι πολύ σοβαρό. Σε άλλα περιστατικά, η διάγνωση έγινε (και εξέπληξε τόσο τους ιδιοκτήτες όσο και εμάς) από μια "απλή" χωλότητα και πρήξιμο στο πόδι (ή στα πόδια ) του ζώου και αυτό ήταν το μοναδικό στοιχείο που αναφέρθηκε στο ιστορικό!
Αξιοσημείωτο είναι επίσης, πως στην πλειοψηφία των περιστατικών που διαγνώσαμε με βαριά Ερλιχίωση στο ιατρείο μας, η απάντηση στην ερώτηση αν βρέθηκαν τσιμπούρια πάνω στο ζώο είτε πρόσφατα είτε στο παρελθόν, ήταν αρνητική!
Εδώ λοιπόν, θα ήθελα να τονίσω και να κάνω σαφές το εξής:
ΔΕΝ ΕΙΝΑΙ ΑΠΑΡΑΙΤΗΤΟ ΝΑ ΒΡΕΘΟΥΝ ΤΣΙΜΠΟΥΡΙΑ ΠΑΝΩ ΣΕ ΕΝΑ ΖΩΟ ΓΙΑ ΝΑ ΠΡΟΣΒΛΗΘΕΙ ΑΠΟ ΤΗΝ ΑΣΘΕΝΕΙΑ ΤΗΣ ΕΡΛΙΧΙΩΣΗΣ!!! Η νόσος μεταδίδεται μέσω τσιμπήματος . Αυτό σημαίνει πως οποιαδήποτε στιγμή το ζώο σας θα μπορούσε να έχει δεχθεί τσίμπημα από τσιμπούρι χωρίς αυτό να ζει απαραίτητα επάνω του!!!
ΜΗΝ ΑΠΟΚΛΕΙΕΤΕ ΤΗΝ ΠΙΘΑΝΟΤΗΤΑ ΤΟ ΖΩΟ ΣΑΣ ΝΑ ΝΟΣΕΙ ΑΠΟ ΕΡΛΙΧΙΩΣΗ ΜΟΝΟ ΚΑΙ ΜΟΝΟ ΕΠΕΙΔΗ ΔΕΝ ΕΤΥΧΕ ΠΟΤΕ ΝΑ ΔΕΙΤΕ ΕΠΑΝΩ ΤΟΥ ΤΣΙΜΠΟΥΡΙ!
Στο άρθρο αυτό ελπίζω να βρείτε χρήσιμες πληροφορίες σχετικά με την αιτιολογία, συμπτωματολογία, διάγνωση , αντιμετώπιση και πρόληψη της επικίνδυνης αυτής ασθένειας. Επιθυμία μου είναι οι ιδιοκτήτες σκύλων να μάθουν για την Ερλιχίωση απλά διαβάζοντας το άρθρο μου και όχι γιατί το ζώο τους νόσησε από αυτήν!
Πολύ περισσότερο όμως αποσκοπώ στην ευαισθητοποίηση των αναγνωστών και ιδιοκτητών σκύλων, είτε ζουν είτε επισκέπτονται συχνά ενδημικές περιοχές, σχετικά με την τεράστια ανάγκη σωστής πρόληψης και καταπολέμησης των εξωπαρασίτων (ψύλλων και τσιμπουριών ), ιδίως κατά την καλοκαιρινή περίοδο.
-ΤΙ ΕΙΝΑΙ ΛΟΙΠΟΝ Η ΕΡΛΙΧΙΩΣΗ ΚΑΙ ΠΟΥ ΟΦΕΙΛΕΤΑΙ?
Η Ερλιχίωση του σκύλου, είναι μια πολύ σοβαρή ασθένεια του αιμοποιητικού συστήματος (αίματος) που οφείλεται σε μικροοργανισμούς (υποχρεωτικά ενδοκυτταρικά βακτήρια) οι οποίοι μεταδίδονται στο σκύλο μέσω των τσιμπουριών και εισέρχονται στα κύτταρα του αίματος του ζώου.
Οι μικροοργανισμοί αυτοί ανήκουν στην τάξη Rickettsiales και οι 2 πιο σημαντικές οικογένειές τους είναι οι: Rickettsiaceae και Anaplasmataceae. Στην οικογένεια Anaplasmataceae ανήκουν και τα πιο σημαντικά (τόσο για την Κτηνιατρική όσο και για την Ανθρώπινη ιατρική) είδη : Η Ehrlichia canis, η Ehrlichia ewingii και η Ehrlichia chaffeensis.
Τα είδη των μικροοργανισμών αυτών, διαφέρουν ως προς τον "φορέα" τους (διαφορετικά είδη τσιμπουριών ), τον "ξενιστή" τους (ζωικό είδος που προσβάλλουν: σκύλος, άνθρωπος, άλογο κα.), αλλά και το είδος των κυττάρων του αίματος που προσβάλλουν.
Η μέχρι τώρα έρευνα βέβαια, έχει αποδείξει πως είναι δυνατή η ταυτόχρονη ή διαδοχική προσβολή του ίδιου ζωικού είδους, από διαφορετικά είδη Ehrlichia !!! Ευτυχώς, είναι σχεδόν όλα ευαίσθητα στην ίδια ομάδα αντιβιοτικών φαρμάκων και η κλινική εικόνα που προκαλούν στον προσβληθέντα οργανισμό καθώς και οι αιματολογικές διαταραχές, δεν διαφέρουν πολύ μεταξύ των ειδών της Ehrlichia (γεγονός πολύ σημαντικό για τη διάγνωση της νόσου!).
H Ehrlichia canis είναι το συχνότερο αίτιο και προκαλεί την πιο σοβαρή μορφή της νόσου στο σκύλο (Μονοκυτταρική Ερλιχίωση). Η E.canis ταυτοποιήθηκε για πρώτη φορά το 1935 και το ενδιαφέρον για τη συγκεκριμένη νόσο αυξήθηκε κατά την διάρκεια του πολέμου στο Βιετνάμ, όταν εκατοντάδες στρατιωτικοί σκύλοι (κυρίως Γερμανικοί Ποιμενικοί ) πέθαναν εξαιτίας της.
Η E.canis έχει παγκόσμια εξάπλωση (Ασία, Αφρική, Ευρώπη, Αμερική), ιδίως σε χώρες όπου λόγω κλιματικών συνθηκών, τα τσιμπούρια "ευδοκιμούν"!
Χώρες όπως το Ηνωμένο Βασίλειο που κατάφεραν να τηρήσουν για πολλά χρόνια την τακτική της "καραντίνας", είναι ακόμα απαλλαγμένες από την συγκεκριμένη νόσο, παρά την παρουσία τσιμπουριών και σε αυτές τις χώρες.
Ο μικροοργανισμός μεταδίδεται μέσω τσιμπήματος από τσιμπούρι, όταν αυτό λαμβάνει ένα "γεύμα" αίματος από μολυσμένο σκύλο (πιο σωστά, από σκύλο που νοσεί στην οξεία φάση της Ερλιχίωσης).
Συγκεκριμένα, πρόκειται για το καφέ τσιμπούρι - Rhipicephalus sanguineus, που έχει παγκόσμια εξάπλωση και σε αντίθεση με άλλα είδη τσιμπουριών μπορεί να επιβιώσει σε κλειστούς χώρους καθ'όλο τον βιολογικό του κύκλο! Είναι το τσιμπούρι που βρίσκεται πιο συχνά σε σπίτια και εκτροφεία. (Το ίδιο τσιμπούρι μπορεί να μεταδώσει και την Babesia canis, καθώς και το Anaplasma platys. Διαφορετικοί παθογόνοι παράγοντες που όμως προκαλούν ίδια ή σχεδόν ίδια με την Ερλιχίωση ασθένεια).

Όταν το τσιμπούρι λάβει το μολυσμένο αίμα, το μεταφέρει στον επόμενο σκύλο "θύμα" που θα τσιμπήσει. Το τσιμπούρι μπορεί να μολυνθεί σε όλα τα στάδια του βιολογικού του κύκλου!!!

(Φωτό. δανεισμένη από το διαδίκτυο)

(ΦΩΤΟ. από αρχείο Ιατρείου)
Το τσιμπούρι διατηρεί την ικανότητά του να μεταδίδει την Ερλίχια για 155 ημέρες μετά τη μόλυνσή του! Έτσι, συμβάλλει όχι μόνο στην μετάδοση της νόσου, αλλά και στην διατήρησή της στο περιβάλλον. Προκειμένου να επιβιώσει το μικρόβιο αυτό μέσα στο σκύλο, θα πρέπει να εισέλθει στα κύτταρα του αίματος του ζώου (και πιο ειδικά στα Λευκά κύτταρα του αίματος) , όπου πολλαπλασιάζεται και μετά διασπείρεται. Η E.canis συγκεκριμένα προσβάλλει τα μακροφάγα κύτταρα.
E.canis μέσα σε μακροφάγο κύτταρο.(φωτό. δανεισμένη από το διαδίκτυο)
Ehrlichia spp. μέσα σε ουδετερόφιλο κύτταρο. (Φωτο: δανεισμένη από διαδίκτυο)
Ehrlichia ewingii μέσα σε ουδετερόφιλο κύτταρο.( Φωτο: δανεισμένη από διαδίκτυο)
Η μεσολάβηση του τσιμπουριού λοιπόν, είναι ΑΠΑΡΑΙΤΗΤΗ για τη μετάδοση της νόσου από σκύλο σε σκύλο. Θεωρητικά δηλαδή, υγιείς σκύλοι που ζουν σε περιοχές "ελεύθερες" τσιμπουριών, δεν κινδυνεύουν από την συνύπαρξή τους με μολυσμένους σκύλους που έχουν μεταναστεύσει στην περιοχή τους.
Ένας άλλος τρόπος μεταφοράς της νόσου από σκύλο σε σκύλο είναι η μετάγγιση αίματος. Γι'αυτό ακριβώς το λόγο, στη χώρα μας όπου η νόσος ενδημεί, θα πρέπει πριν από κάθε μετάγγιση αίματος σε σκύλο να γίνεται εξέταση αίματος του δότη για τη συγκεκριμένη νόσο!!!
Η Ehrlichia ewingii, (διαδεδομένη στις ΗΠΑ), φαίνεται πως προκαλεί την λιγότερο σοβαρή μορφή της νόσου στο σκύλο όπου ανάμεσα στα συμπτώματα κυριαρχούν οι πολυαρθρίτιδες, αλλά μπορεί να προσβάλλει και τον άνθρωπο. Φορέας του είναι το Amblyomma americanum (Lone star tick).
Η Ehrlichia chaffeensis θεωρείται ο αιτιολογικός παράγοντας της Ανθρώπινης μονοκυτταρικής Ερλιχίωσης. Μεταδίδεται από το Ambylomma americanum (Lone star tick), ένα πολύ επιθετικό είδος τσιμπουριού που προσβάλλει πολλά διαφορετικά ζωικά είδη και τον άνθρωπο.
-ΤΙ ΓΙΝΕΤΑΙ ΜΕΤΑ ΤΗ ΜΟΛΥΝΣΗ ΤΟΥ ΣΚΥΛΟΥ ΑΠΟ ΤΗΝ ΕΡΛΙΧΙΑ?
Κάτι πολύ σημαντικό που θεωρώ πως πρέπει να τονίσουμε εξαρχής (και που ίσως έχετε ξαναδεί να αναφέρω συχνά στο άρθρο της Λεϊσμανίωσης ), είναι πως η εξέλιξη της ασθένειας από την στιγμή που θα μολυνθεί ο σκύλος, έχει να κάνει με πολλούς παράγοντες, μεταξύ των οποίων είναι:
1.Το είδος και η δύναμη του μικροοργανισμού που θα τον προσβάλλει (διαφορετικά είδη Erhlichia ).
2. Άλλες ασθένειες από τις οποίες το ζώο νοσεί ταυτόχρονα.
3. Ο σημαντικότερος παράγοντας όλων όμως, είναι Η ΥΓΕΙΑ ΚΑΙ ΔΥΝΑΜΗ ΤΟΥ ΑΝΟΣΟΠΟΙΗΤΙΚΟΥ ΣΥΣΤΗΜΑΤΟΣ ΤΟΥ ΙΔΙΟΥ ΤΟΥ ΣΚΥΛΟΥ!!!!!
Δεν θεωρώ σε καμία περίπτωση τυχαίο το γεγονός πως ένας μεγάλος αριθμός σκύλων που ελέγχθηκαν αιματολογικά είχαν και τις δύο ασθένειες ταυτόχρονα : Λεϊσμανίωση και Ερλιχίωση.
Όσοι επισκέπτεστε την ιστοσελίδα ή το ιατρείο μας, θα διαβάζετε ή θα μας ακούτε ΣΥΧΝΑ (και ίσως λίγο κουραστικά) , να επαναλαμβάνουμε την ίδια συμβουλή!
Φροντίζετε ώστε τα κατοικίδιά σας να είναι ελεύθερα παρασίτων (σκουλήκια εντέρου, ψύλλοι, τσιμπούρια) και κάνετε τους απαραίτητους ΕΤΗΣΙΟΥΣ εμβολιασμούς και κτηνιατρικούς ελέγχους.
ΕΝΑ ΥΓΙΕΣ ΚΑΤΑ ΤΑ ΑΛΛΑ ΖΩΟ, ΕΧΕΙ ΠΕΡΙΣΣΟΤΕΡΕΣ ΠΙΘΑΝΟΤΗΤΕΣ ΝΑ ΑΝΤΙΜΕΤΩΠΙΣΕΙ ΜΙΑ ΑΣΘΕΝΕΙΑ ΟΠΩΣ Η ΕΡΛΙΧΙΩΣΗ Ή Η ΛΕΪΣΜΑΝΙΩΣΗ ΟΤΑΝ ΤΟ ΑΝΟΣΟΠΟΙΗΤΙΚΟ ΤΟΥ ΣΥΣΤΗΜΑ ΕΙΝΑΙ ΓΕΡΟ ΚΑΙ ΔΥΝΑΤΟ. ΑΝΤΙΘΕΤΑ, ΕΝΑ ΖΩΟ ΠΟΥ ΥΠΟΦΕΡΕΙ ΑΚΟΜΑ ΚΑΙ ΑΠΟ ΤΑ "ΑΠΛΑ" ΣΚΟΥΛΗΚΙΑ ΤΟΥ ΕΝΤΕΡΟΥ, ΕΧΕΙ ΕΝΑ ΑΔΥΝΑΜΟ ΚΑΙ ΕΥΑΛΩΤΟ ΑΝΟΣΟΠΟΙΗΤΙΚΟ ΣΥΣΤΗΜΑ ΠΟΥ ΔΕΝ ΘΑ ΜΠΟΡΕΣΕΙ ΤΕΛΙΚΑ ΝΑ ΑΝΤΑΠΟΚΡΙΘΕΙ ΑΚΟΜΑ ΚΑΙ ΜΕΤΑ ΤΗΝ ΧΟΡΗΓΗΣΗ "ΑΚΡΙΒΩΝ" ΦΑΡΜΑΚΩΝ!!!!!!!!!!!!!
Ανοσοκατεσταλμένα ζώα θα εκδηλώσουν την Ερλιχίωση στην πιο βαριά της μορφή. Το φύλο ή η ηλικία του ζώου ΔΕΝ παίζουν κανέναν ρόλο στη μόλυνση από την Ερλίχια. Σε ότι αφορά τις φυλές των σκύλων, η έρευνα έχει δείξει πως ο Γερμανικός Ποιμενικός (German Shepherd dog) είναι πιο ευαίσθητος σε σχέση με άλλες φυλές και η νόσος, όταν εκδηλωθεί σε αυτούς τους σκύλους, έχει πολύ πιο δυσμενή εξέλιξη και κακή πρόγνωση. Η διαφορά μεταξύ των φυλών στην εκδήλωση και εξέλιξη της ασθένειας, έχει να κάνει με την ικανότητα ανταπόκρισης του ανοσοποιητικού τους συστήματος. Για τον Γερμανικό Ποιμενικό συγκεκριμένα, έχει βρεθεί ότι η κυτταρική ανοσία του απέναντι στην E.canis είναι μειωμένη σε σχέση με την φυλή Beagle για παράδειγμα!
Ο χρόνος επώασης,(από την στιγμή που θα τσιμπηθεί το ζώο μέχρι που θα εκδηλώσει τα πρώτα συμπτώματα), είναι συνήθως 8-20 ημέρες. Μέσα σε αυτό το χρονικό διάστημα, οι μικροοργανισμοί πολλαπλασιάζονται μέσα στα κύτταρα του αίματος και διασπείρονται στο σώμα του σκύλου.
Η συμβουλή μου προς όλους τους ιδιοκτήτες σκύλων είναι να ζητούν την βοήθεια του Κτηνιάτρου τους και να γίνεται εξέταση αίματος στο ζώο τους μέσα σε ένα μήνα το αργότερο από την ανεύρεση τσιμπουριού επάνω του και φυσικά πολύ νωρίτερα, αν το ζώο έχει εκδηλώσει σημάδια αδιαθεσίας!!!
-ΠΩΣ ΕΚΔΗΛΩΝΕΤΑΙ Η ΕΡΛΙΧΙΩΣΗ ΣΤΟ ΣΚΥΛΟ?
Όλα τα παρακάτω αναφερόμενα κλινικά σημεία και συμπτώματα αφορούν κυρίως στην προσβολή ενός σκύλου από την E.canis (το συχνότερο είδος που προσβάλλει τον σκύλο).Είναι σημαντικό να επαναλάβουμε και να διευκρινίσουμε πως η ασθένεια της Ερλιχίωσης μπορεί να οφείλεται σε διαφορετικά είδη του γένους Ehrlichia, όπως επίσης σημαντικό είναι να τονίσουμε πως άλλες, παρόμοιες ασθένειες με την Ερλιχίωση είναι δυνατό να μεταδοθούν από τα τσιμπούρια και η διάγνωσή τους απαιτεί ειδικές εργαστηριακές εξετάσεις.
Από μελέτες σε πειραματικό επίπεδο στους σκύλους, έχουν διαπιστωθεί 3 φάσεις της νόσου της Ερλιχίωσης:
1.ΟΞΕΙΑ
2.ΥΠΟΚΛΙΝΙΚΗ
3.ΧΡΟΝΙΑ
Ο διαχωρισμός αυτός βασίζεται στην εκδήλωση κλινικών σημείων και συμπτωμάτων καθώς και σε αιματολογικές διαταραχές που εκδηλώνονται μετά την προσβολή του ζώου από Ερλιχίωση, επαναλαμβάνω σε ΠΕΙΡΑΜΑΤΙΚΕΣ συνθήκες.
Στις φυσικές λοιμώξεις, ο διαχωρισμός της νόσου στις παραπάνω φάσεις είναι δύσκολος. Παρόλαυτά, η λήψη ενός λεπτομερούς και πλήρους ιστορικού σε συνδυασμό με την προσεκτική κλινική εξέταση του ζώου από έναν έμπειρο Κτηνίατρο που γνωρίζει σε βάθος τη νόσο της Ερλιχίωσης, επιτρέπει ακόμα και σε φυσικές λοιμώξεις την έγκαιρη διάγνωση.
Στη χώρα μας, όπου οι κλιματικές συνθήκες επιτρέπουν την επιβίωση των τσιμπουριών ακόμα και το χειμώνα, η Ερλιχίωση θα πρέπει να αποτελεί μέρος της διαφορικής διάγνωσης σχεδόν σε κάθε ζώο που παρουσιάζεται με ύποπτη κλινική εικόνα, τόσο κατά τους καλοκαιρινούς μήνες, όσο και αμέσως μετά την θερινή περίοδο. Η πεποίθηση πως τα τσιμπούρια ζουν μόνο το καλοκαίρι είναι εντελώς εσφαλμένη, αλλά στην συγκεκριμένη περίπτωση δεν θα είχε καμία απολύτως σημασία ακόμα κι ήταν έτσι. Η νόσος μεταδίδεται μέσω τσιμπήματος και έχει ένα χρόνο επώασης 8-20 ημέρες. Από εκεί και μετά, το πότε θα εκδηλώσει τη νόσο το ζώο, εξαρτάται από πολλούς παράγοντες! Ένα ζώο μπορεί να τσιμπηθεί το καλοκαίρι και να νοσήσει μέσα στον επόμενο χειμώνα ή ακόμα και μετά από πολλούς μήνες έως και χρόνια! Έτσι λοιπόν, για κάθε ζώο που έχει ύποπτη κλινική εικόνα, η Ερλιχίωση θα πρέπει να μπαίνει στη "λίστα" με τα πιθανά αίτια, ανεξαρτήτως "εποχής" (***απαραίτητη διευκρίνηση ώστε ο τίτλος του άρθρου "ΚΑΛΟΚΑΙΡΙΝΟΣ ΕΦΙΑΛΤΗΣ" να μην είναι παραπλανητικός).
Ακόμα καλύτερα, πιστεύω πως τώρα πια και με βάση την προσωπική μου στατιστική από τον αριθμό των ζώων που έχουμε ήδη διαγνώσει με τη νόσο της Ερλιχίωσης στο ιατρείο μας, ίσως θα πρέπει στον ετήσιο προληπτικό αιματολογικό έλεγχο του ζώου που γίνεται κάθε χειμώνα για τη Λεϊσμανίωση, να προστεθεί και η Ερλιχίωση. Η συμβουλή αυτή αφορά όχι μόνο στα ζώα που διαμένουν σε ενδημικές περιοχές, αλλά και σε εκείνα που ταξιδεύουν προς αυτές!
1.ΟΞΕΙΑ ΦΑΣΗ
Η οξεία φάση διαρκεί περίπου 2-4 εβδομάδες (το χρονικό διάστημα δεν είναι σταθερό). Τα κλινικά σημεία και συμπτώματα που εκδηλώνει το ζώο στη φάση αυτή, ΙΣΩΣ να γίνουν αντιληπτά από τον ιδιοκτήτη, ο οποίος αν ζητήσει έγκαιρα την βοήθεια κτηνιάτρου θα καταφέρει να σώσει το ζώο του. Η βαρύτητα της κλινικής εικόνας του ζώου που εισέρχεται στην οξεία φάση της Ερλιχίωσης και πάλι εξαρτάται από πολλούς παράγοντες και ΔΕΝ είναι η ίδια για όλα τα ζώα.
Τα πιο συνήθη συμπτώματα της οξείας φάσης είναι: πυρετός, ανορεξία, κατάπτωση, λήθαργος. Σπανιότερα ένα ζώο με πιο αδύναμο ανοσοποιητικό σύστημα θα εκδηλώσει ακόμα από την οξεία φάση τα πιο σοβαρά κλινικά σημεία της Ερλιχίωσης όπως: πετέχειες και εκχυμώσεις (μικροαιμορραγίες σε δέρμα και βλεννογόνους), επίσταξη (αιμορραγία από τη μύτη), λεμφαδενομεγαλία, σπληνομεγαλία.
Συμπτώματα από το Κεντρικό Νευρικό Σύστημα μπορεί να επίσης να εκδηλωθούν κατά την οξεία φάση της Ερλιχίωσης και ανάμεσά τους ξεχωρίζουν η ΥΠΕΡΑΙΣΘΗΣΙΑ και ήπια εκδήλωση μυικών τρόμων. Η ΥΠΕΡΑΙΣΘΗΣΙΑ, είναι ένα από τα πιο "εντυπωσιακά" κλινικά σημεία της Ερλιχίωσης που συχνά είναι το μόνο αναφερόμενο από τον ιδιοκτήτη του ζώου σύμπτωμα. Χαρακτηριστικά ο ιδιοκτήτης αναφέρει πως το ζώο μοιάζει να πονάει....."ΠΑΝΤΟΥ". Συχνά οι ιδιοκτήτες τέτοιων ζώων αναφέρουν έντονη αντίδραση του ζώου και "κλάμα" στο απλό άγγιγμα ή χάδι!!!!! Τα ζώα αυτά αρνούνται να σηκωθούν ή να περπατήσουν και προτιμούν να παραμένουν καθισμένα ή ξαπλωμένα.
Αλήθεια είναι πως λίγοι ιδιοκτήτες αναζητούν την βοήθεια Κτηνιάτρου με την πρώτη βραχείας διάρκειας αδιαθεσία του ζώου τους. Αλλά ακόμα και τότε, πολύ συχνά, χρειάζεται επιμονή και προσπάθεια από μέρους του Κτηνιάτρου για να πείσει τον ιδιοκτήτη του ζώου να κάνει τις απαραίτητες εξετάσεις αίματος στο ζώο του, ιδίως όταν ο τελευταίος επιμένει πως Ποτέ μα Ποτέ δεν βρήκε τσιμπούρι επάνω στο ζώο του!!!!!!!!!!!
Από την κλινική μου εμπειρία και πάλι, τα ζώα που διαγνώσθηκαν έγκαιρα κατά την οξεία φάση της Ερλιχίωσης ήταν αυτά που παρουσιάσθηκαν με ήπια κλινική εικόνα και συμπτώματα που περιορίζονταν σε ελαφρά μείωση της όρεξης για φαγητό και ήπιας κούρασης, στις περισσότερες περιπτώσεις αποδιδόμενη στην καλοκαιρινή ζέστη από τον ιδιοκτήτη. Σε αυτά τα περιστατικά, χάρη στην δική μας επιμονή ο ιδιοκτήτης του ζώου προχώρησε σε αιματολογικές εξετάσεις όπου και επιβεβαιώθηκε η νόσος.
Να θυμάστε: ΔΕΝ ΕΙΝΑΙ ΑΠΑΡΑΙΤΗΤΗ Η ΠΑΡΟΥΣΙΑ ΤΣΙΜΠΟΥΡΙΟΥ ΕΠΑΝΩ ΣΕ ΕΝΑ ΖΩΟ ΓΙΑ ΝΑ ΓΙΝΕΙ ΔΙΑΓΝΩΣΗ ΤΗΣ ΕΡΛΙΧΙΩΣΗΣ. Η ΝΟΣΟΣ ΜΕΤΑΔΙΔΕΤΑΙ ΜΕ ΑΠΛΟ ΤΣΙΜΠΗΜΑ ΑΠΟ ΤΣΙΜΠΟΥΡΙ!
Τα περισσότερα ζώα πλέον προστατεύονται από αμπούλες , χάπια και σπρέυ κατά των εξωπαρασίτων. Εκεί όμως που γίνεται η παρεξήγηση από μέρους των ιδιοκτητών είναι πως τα προϊόντα καταπολέμησης εξωπαρασίτων αποτρέπουν την "επίθεση" στα ζώα τους από ψύλλους και τσιμπούρια.
ΛΑΘΟΣ!!!
Δυστυχώς, τα προϊόντα καταπολέμησης ψύλλων και τσιμπουριών ΔΕΝ έχουν απωθητική δράση. Δεν διώχνουν τα εξωπαράσιτα πριν αυτά πλησιάσουν το ζώο, αλλά τα σκοτώνουν αφού αυτά επιτεθούν στο ζώο και το τσιμπήσουν. Μέχρι και σήμερα (2016), κανένα προϊόν καταπολέμησης εξωπαρασίτων δεν έχει αποδεδειγμένα απωθητική δράση. Προσπάθειες και έρευνες έχουν γίνει και εξακολουθούν να γίνονται προς αυτή την κατεύθυνση και θα είναι μεγάλη ανακούφιση αν στο μέλλον υπάρξει ένα τέτοιο προϊόν.
Ο ψύλλος και το τσιμπούρι ΔΕΝ αναγνωρίζουν πως το ζώο σας έχει επάνω του εξωπαρασιτοκτόνο. Το τσιμπούρι θα ανέβει, θα τσιμπήσει και μετά θα πέσει νεκρό. Τσίμπησε όμως! δηλαδή έλαβε ένα "γεύμα" αίματος από το σκύλο άρα, υπάρχει σοβαρή πιθανότητα να μετέδωσε την ασθένεια!
Πολλές αναφορές γίνονται σε σκευάσματα που περιέχουν αιθέρια έλαια τα οποία έχουν εντομοαπωθητική δράση. Τα σκευάσματα αυτά έχουν αποτελεσματική δράση στην απώθηση εντόμων (κουνουπιών και σκνιπών), όμως τα τσιμπούρια και οι ψύλλοι ΔΕΝ είναι έντομα. Αυτή είναι μια ακόμα παρεξήγηση που συχνά οδηγεί τους ιδιοκτήτες σκύλων σε λάθος τακτικές καταπολέμησης των ψύλλων και τσιμπουριών.
Άλλα σκευάσματα διώχνουν τις σκνίπες και τα κουνούπια και άλλα τους ψύλλους και τα τσιμπούρια!!!!!!!!
Αιματολογικές αλλαγές που πιθανά να εμφανιστούν σε ένα ζώο με Οξεία Ερλιχίωση είναι: ελαφρά μείωση του αριθμού των αιμοπεταλίων, ήπια λευκοπενία (μείωση των λευκών αιμοσφαιρίων) και ήπια αναιμία.
Τα περισσότερα ζώα που λαμβάνουν έγκαιρα αγωγή κατά την οξεία φάση της νόσου, αναρρώνουν πλήρως. Ζώα των οποίων η διάγνωση θα διαφύγει την οξεία φάση ή ζώα στα οποία χορηγηθεί ΕΛΛΕΙΠΗΣ θεραπεία, είτε αναρρώνουν χάρη στο δυνατό και υγιές ανοσοποιητικό τους σύστημα είτε εισέρχονται στην λεγόμενη ΥΠΟΚΛΙΝΙΚΗ φάση.
2.ΥΠΟΚΛΙΝΙΚΗ ΦΑΣΗ
Στη φάση αυτή, είτε γιατί το ανοσοποιητικό σύστημα κατάφερε να αντιμετωπίσει την αρχική οξεία φάση είτε γιατί η ελάχιστη αλλά ελλειπής θεραπεία που χορηγήθηκε είχε κάποιο αποτέλεσμα, το ζώο δείχνει "καλύτερα" ή ακόμα και εντελώς "καλά"!!!
Το σωματικό βάρος ανακτάται, η όρεξη για φαγητό αποκαθίσταται, ο πυρετός υποχωρεί και γενικά το ζώο έχει και πάλι Υγιή κλινική εικόνα.
ΑΥΤΗ ΑΚΡΙΒΩΣ ΕΙΝΑΙ ΚΑΤΑ ΤΗ ΓΝΩΜΗ ΜΟΥ Η "ΠΑΓΙΔΑ" ΤΗΣ ΕΡΛΙΧΙΩΣΗΣ!
Τα ζώα δηλαδή που από "τύχη" καταφέρνουν να διαφύγουν την οξεία φάση της Ερλιχίωσης και που το ανοσοποιητικό τους σύστημα δεν καταφέρει να εξαλείψει εντελώς τη νόσο, θα εκδηλώσουν στο μέλλον την βαριά "χρόνια μορφή" και ένα μεγάλο ποσοστό από αυτά θα καταλήξει, αν και πάλι δεν γίνει έστω και καθυστερημένα η σωστή διάγνωση.
Η αποτυχία της έγκαιρης διάγνωσης, οφείλεται είτε στην αμέλεια του ιδιοκτήτη που βλέποντας το ζώο του να αναρρώνει από την βραχεία αδιαθεσία του δεν ζητά βοήθεια από Κτηνίατρο, είτε στην απειρία του Κτηνιάτρου που δεν υποψιάστηκε τη νόσο, είτε στην άρνηση του ιδιοκτήτη να προχωρήσει σε αιματολογικές εξετάσεις παρά την επιμονή του Κτηνιάτρου ο οποίος συχνά κατηγορείται από τους ιδιοκτήτες για ιδιοτελή-οικονομικά κίνητρα!
Στην υποκλινική φάση, απουσιάζουν τα κλινικά σημεία εκείνα που θα υποστήριζαν την υποψία και διάγνωση της ασθένειας. Μόνον στην αιματολογική εικόνα του ζώου, μια ελαφρά μείωση του συνόλου των αιμοπεταλίων θα μπορούσε να θέσει την υποψία. Έτσι, θεωρείται απαραίτητη η πραγματοποίηση ειδικής ορολογικής εξέτασης που θα αποκαλύψει τον τίτλο αντισωμάτων κατά της Ερλιχίωσης!
Η χρονική διάρκεια της υποκλινικής φάσης ποικίλλει. Σε ορισμένες περιπτώσεις το ζώο μπορεί να παραμείνει φορέας της νόσου για χρόνια. Η έρευνα έχει αποδείξει πως οι μικροοργανισμοί της Ehrlichia μπορεί να παραμένουν (και να "κρύβονται") για χρόνια στον σπλήνα του ζώου. Γι'αυτό και σε πειραματικές μολύνσεις παρατηρήθηκε πως ζώα που είχαν υποστεί σπληνεκτομή εκδήλωσαν μόνον την ήπια μορφή της νόσου. Τα ζώα αυτά μπορούν να μεταφέρουν κατά τις μετακινήσεις τους τη νόσο από ενδημικές σε μη ενδημικές περιοχές!!!
3.ΧΡΟΝΙΑ ΦΑΣΗ
Η χρόνια φάση, στη σοβαρή της μορφή χαρακτηρίζεται από καταστολή του Μυελού των οστών και μειωμένη παραγωγή κυττάρων του αίματος που καταλήγει σε Πανκυτταροπενία (μείωση όλων των λευκών αιμοσφαιρίων του ζώου). Η πρόγνωση για τα ζώα που θα εισέλθουν στην χρόνια φάση είναι δυσμενής. Πολλά από τα ζώα αυτά τελικά θα πεθάνουν από σοβαρές δευτερογενείς λοιμώξεις ή από ανεξέλεγκτες αιμορραγίες (ή και τα δύο).
ΓΙ'ΑΥΤΟ ΑΚΡΙΒΩΣ ΤΟ ΛΟΓΟ ΤΟΝΙΖΩ ΤΗΝ ΑΝΑΓΚΑΙΟΤΗΤΑ ΠΡΟΛΗΠΤΙΚΩΝ ΑΙΜΑΤΟΛΟΓΙΚΩΝ ΕΛΕΓΧΩΝ ΓΙΑ ΤΗΝ ΕΓΚΑΙΡΗ ΔΙΑΓΝΩΣΗ ΤΗΣ ΕΡΛΙΧΙΩΣΗΣ!
Φυσικά, το ίδιο σημαντικό είναι να γίνεται η κατά το δυνατό σωστή αγωγή κατά των εξωπαρασίτων (ψύλλοι και τσιμπούρια).
-ΠΟΙΑ ΕΙΝΑΙ ΤΑ ΚΛΙΝΙΚΑ ΣΗΜΕΙΑ ΚΑΙ ΣΥΜΠΤΩΜΑΤΑ ΤΗΣ ΕΡΛΙΧΙΩΣΗΣ?
Τα παρακάτω κλινικά σημεία και συμπτώματα αφορούν στη μόλυνση του σκύλου από την Erhlichia canis, αν και όπως ανέφερα ήδη, τα περισσότερα είδη της Ehrlichia προκαλούν παρόμοιες κλινικές εκδηλώσεις.
Η Ερλιχίωση του σκύλου περιγράφεται ως ΠΟΛΥΣΥΣΤΗΜΑΤΙΚΗ νόσος. Εκδηλώνεται δηλαδή με ένα πλήθος συμπτωμάτων από όλα σχεδόν τα συστήματα του οργανισμού του ζώου.
Εδώ θα πρέπει να τονίσω ιδιαίτερα, πως και στην Ερλιχίωση (όπως και στη Λεϊσμανίωση), ΔΕΝ ΥΠΑΡΧΟΥΝ ΕΙΔΙΚΑ ΣΥΜΠΤΩΜΑΤΑ ΚΑΙ ΚΛΙΝΙΚΑ ΣΗΜΕΙΑ ΠΟΥ ΝΑ ΧΑΡΑΚΤΗΡΙΖΟΥΝ ΤΗ ΝΟΣΟ!!!
Υπάρχουν συχνότερα και περισσότερο χαρακτηριστικά συμπτώματα, τα οποία όμως θα μπορούσαν να εμφανιστούν και σε ένα πλήθος άλλων παθολογικών καταστάσεων.
Τα συχνότερα εμφανιζόμενα λοιπόν κλινικά σημεία και συμπτώματα της ΕΡΛΙΧΙΩΣΗΣ είναι:
1.Κατάπτωση, λήθαργος, ανορεξία και ελαφρά μείωση του σωματικού βάρους.
2. ΑΙΜΟΡΡΑΓΙΕΣ!!!!!!!!!!!!!
Τις αιμορραγίες τις τονίζω ιδιαίτερα, διότι θεωρούνται από τα πιο χαρακτηριστικά κλινικά σημεία της Ερλιχίωσης. Η πιο συχνά εμφανιζόμενη είναι η αιμορραγία από τη μύτη του ζώου-ΕΠΙΣΤΑΞΗ!

(ΦΩΤΟ. από αρχείο Ιατρείου)
Είναι δε τόσο χαρακτηριστική που συχνά αναφέρεται ως παθογνωμονικό (ειδικό) της νόσου κλινικό σημείο.
Η προσωπική μου γνώμη όμως είναι πως η αιμορραγία από τη μύτη, σίγουρα θα πρέπει να θέτει ΑΜΕΣΑ υποψία Ερλιχίωσης σκύλους που ζουν ή έχουν ταξιδέψει σε ενδημικές της νόσου περιοχές, αλλά σε καμία περίπτωση να μην παραβλέπονται άλλα πιθανά αίτια όπως:
♦ Λεϊσμανίωση.
♦Δηλητηρίαση από ποντικοφάρμακο!
♦Αυτοάνοση Θρομβοκυτταροπενία.
♦Όγκοι (καλοήθεις ή κακοήθεις).
♦Ξένα σώματα.
κτλ.
Εκτός από τη μύτη, ένα ζώο προσβεβλημένο από Ερλιχίωση, μπορεί να αιμορραγεί και από άλλες οδούς τους σώματός του όπως το στόμα, τη γεννητική οδό, την ουροποιητική οδό, το έντερο (κατά την αφόδευση).
Οι αιμορραγίες εκφράζονται εργαστηριακά με ένδειξη ΑΝΑΙΜΙΑΣ στη γενική εξέταση αίματος, που είναι ΑΝΑΓΕΝΝΗΤΙΚΗ στην περίπτωση της ΟΞΕΙΑΣ φάσης της νόσου ενώ ΜΗ ΑΝΑΓΕΝΝΗΤΙΚΗ στην ΧΡΟΝΙΑ φάση.

(Μέλαινα: κόπρανα σκύλου με αίμα εξαιτίας βαριάς χρόνιας Ερλιχίωσης. Φωτό. από αρχείο Ιατρείου)
Οι αιμορραγίες όμως ΔΕΝ είναι πάντοτε τόσο προφανείς! Μπορεί να εκδηλωθούν με την μορφή "πετεχειών" και "εκχυμώσεων" στο δέρμα και τους βλεννογόνους του ζώου!
Αυτές είναι μικρές, "στικτές" αιμορραγίες (μεγέθους κεφαλιού καρφίτσας) ως αποτέλεσμα μικροτραυματισμών, που εμφανίζονται είτε στο δέρμα του ζώου είτε μέσα στο στόμα (ούλα, έσω επιφάνεια χειλιών). Οι πετέχειες δεν γίνονται εύκολα αντιληπτές από τον ιδιοκτήτη, παρά μόνον στα άτριχα σημεία του σώματος ή σε πολύ κοντότριχα ζώα. Συχνά, οι ιδιοκτήτες τέτοιων ζώων ερμηνεύουν τις αιμορραγίες αυτές ως δερματολογικό πρόβλημα (αλλεργία) και δυστυχώς καθυστερούν την εξέταση του ζώου από Κτηνίατρο εφαρμόζοντας διάφορα τοπικά δερματολογικά σκευάσματα!
Εδώ θα πρέπει να αναφέρω πως όταν πια το ζώο έχει αρχίσει να εκδηλώνει αυτά τα κλινικά σημεία, η ασθένεια βρίσκεται σε αρκετά προχωρημένο στάδιο και ίσως ΜΗ ΑΝΤΙΣΤΡΕΠΤΟ!
ΝΑ ΘΥΜΑΣΤΕ: Για οποιοδήποτε "δερματολογικό" πρόβλημα, θα πρέπει να συμβουλεύεσθε τον/την Κτηνίατρό σας! Είναι απολύτως απαραίτητη η επισκόπηση των "δερματολογικών" αλλοιώσεων από Κτηνίατρο προκειμένου να αποφευχθεί η καταστροφική συνέχεια, στην περίπτωση που πρόκειται για μικροαιμορραγίες οφειλόμενες σε ΕΡΛΙΧΙΩΣΗ!
Κάτι πολύ σημαντικό που θα ήταν παράληψη να μην αναφερθεί!
ΤΙΣ ΙΔΙΕΣ ΑΚΡΙΒΩΣ ΚΛΙΝΙΚΕΣ ΕΚΔΗΛΩΣΕΙΣ ΣΕ Ο,ΤΙ ΑΦΟΡΑ ΤΙΣ ΑΙΜΟΡΡΑΓΙΕΣ, ΕΧΕΙ ΚΑΙ Η ΔΗΛΗΤΗΡΙΑΣΗ ΑΠΟ ΠΟΝΤΙΚΟΦΑΡΜΑΚΟ!
Όταν λοιπόν ένα ζώο παρουσιάζεται με αυτή την κλινική εικόνα και ο Κτηνίατρος εξηγεί πως πρέπει να γίνουν ΑΜΕΣΑ τόσο αιματολογικές εξετάσεις όσο και προληπτική αγωγή κατά 2 ή 3 πιθανών αιτίων, ΔΕΝ είναι επειδή δεν ξέρει τι έχει το ζώο σας ο "άσχετος", αλλά γιατί πολύ απλά θα μπορούσαν πραγματικά να συμβαίνουν 1 ή 2 ή 3 πράγματα ταυτόχρονα. Σε αυτές τις περιπτώσεις δυστυχώς για εμάς (και εφόσον ο σκύλος ΔΕΝ "μιλά" για να μας πει πχ. αν έφαγε ποντικοφάρμακο), μόνο ένας Μελλοντολόγος με Κληρονομικό χάρισμα θα μπορούσε να μας διαφωτίσει για το τι ακριβώς συμβαίνει με το ζώο χωρίς να χρειαστεί να γίνουν πολλές εξετάσεις αίματος και λεπτομερής κλινική εξέταση του ζώου. Στις περιπτώσεις αυτές, ο χρόνος είναι πολύτιμος! Ο Κτηνίατρος καλείται να καλύψει το χρόνο που χάθηκε από την καθυστερημένη προσκόμιση του ζώου και γι'αυτό πολύ συχνά εφαρμόζει προληπτική αγωγή κατά πολλαπλών πιθανών αιτίων, μέχρι τα αποτελέσματα των ειδικών εξετάσεων να ρίξουν φως στα πραγματικά αίτια νόσησης του ζώου.
Αλλά ακόμα και όταν εξετάσεις αίματος σε μια τέτοια περίπτωση αιμορραγιών επιβεβαιώνουν την Ερλιχίωση ή ακόμα και τη Λεϊσμανίωση, δεν θα ήταν παράλειψη να μην λάβει κανείς προληπτικά μέτρα για την "τρελλή" εκείνη πιθανότητα το συγκεκριμένο ζώο να έχει καταναλώσει και ποντικοφάρμακο? Ιδίως όταν ο ιδιοκτήτης ΔΕΝ αποκλείει την πιθανότητα το ζώο του να έχει πρόσβαση σε τέτοια δηλητήρια.
Αυτό που προσπαθώ να εξηγήσω είναι πως η κλινική εικόνα ενός ζώου που αιμορραγεί, είναι πραγματικός διαγνωστικός εφιάλτης για τον Κτηνίατρο που πρέπει στην προσπάθειά του να βοηθήσει το ζώο να έχει σύμμαχο τον ιδιοκτήτη. Κανένας Κτηνίατρος δεν θέλει να βλέπει τους ασθενείς του να χάνονται ή να υποφέρουν. Μακάρι η επιστήμη της Κτηνιατρικής να ήταν απλούστερη ή οι "ασθενείς" να μιλούσαν. Τα πράγματα θα ήταν πολύ πιο εύκολα!!!!

(ΠΕΤΕΧΕΙΕΣ στο δέρμα-φωτό. από αρχείο Ιατρείου)

(ΠΕΤΕΧΕΙΕΣ στο βλεννογόνο του στόματος- φωτο. από αρχείο Ιατρείου)
3.Λεμφαδενομεγαλία (διογκωμένοι λεμφαδένες). Και πάλι, ένα κλινικό σημείο που εκδηλώνεται και στη Λεϊσμανίωση.
4.Σπληνομεγαλία (διογκωμένος Σπλήνας). Και πάλι, ένα κλινικό σημείο που εκδηλώνεται και στη Λεϊσμανίωση.
5.Οφθαλμολογικές αλλοιώσεις: αλλαγή του χρώματος των ματιών, αποκόλληση αμφιβληστροειδούς, αιμορραγίες μέσα στα μάτια, ακόμα και αιφνίδια τύφλωση!
6.Νευρολογικές διαταραχές: ως αποτέλεσμα μηνιγγίτιδας λόγω φλεγμονής ή ακόμα και αιμορραγιών που μπορεί να εκδηλωθούν ως επιληπτικές κρίσεις,αταξία, μυική ατροφία, παράλυση κτλ.
7.Πολυαρθρίτιδα
Και την πολυαρθρίτιδα θα την τονίσω ιδιαίτερα, διότι πολύ σπάνια θα υποψιαστεί κανείς τη νόσο της Ερλιχίωσης σε ένα σκύλο που απλώς "κουτσαίνει"!!!!!!!!!!!!!!!!!
Όμως, σε αρκετά περιστατικά που παρουσιάστηκαν στο ιατρείο μας και ενώ το μόνο αναφερόμενο από τον ιδιοκτήτη σύμπτωμα ήταν μια ξαφνική "χωλότητα" ή ένα "πρησμένο πόδι", η τελική διάγνωση ήταν............Ερλιχίωση!
Η χωλότητα και η δυσκολία στο περπάτημα σε ένα ζώο προσβεβλημένο από Ερλιχίωση εξηγείται είτε από την αιμορραγία και συλλογή αίματος σε κάποια άρθρωση, είτε από την εναπόθεση ανοσοσυμπλόκων και την προκληθείσα ΑΡΘΡΙΤΙΔΑ!


-ΠΩΣ ΓΙΝΕΤΑΙ Η ΔΙΑΓΝΩΣΗ ΤΗΣ ΕΡΛΙΧΙΩΣΗΣ?
Η υποψία της νόσου τίθεται όταν κάποιο ή πολλά ή όλα τα παραπάνω κλινικά σημεία και συμπτώματα παρατηρηθούν σε ένα ζώο και το ιστορικό υποστηρίζεται από την παραμονή του ζώου σε μια ενδημική περιοχή. Η επιβεβαίωση της νόσου όμως, είναι πραγματική πρόκληση για τον Κτηνίατρο εξαιτίας τόσο της πολυποίκιλλης κλινικής της εικόνας, όσο και των διαφορετικών ειδών της Ehrlichia που μπορεί να προσβάλλουν το σκύλο.
Όταν σε ένα ζώο τίθεται υποψία Ερλιχίωσης, τότε απαιτούνται ειδικές αιματολογικές εξετάσεις. Ο Κτηνίατρός σας θα ζητήσει κατ'αρχήν να γίνει μια "ΓΕΝΙΚΗ" εξέταση αίματος. Αυτή είναι η εξέταση που εντοπίζει τις πρώτες αιματολογικές αλλαγές. Σε αυτή την εξέταση θα εμφανιστούν "ίσως" οι πρώτες διαταραχές στους αριθμούς συγκεκριμένων κυττάρων του αίματος. Λέξεις δύσκολα κατανοητές όπως: Πανκυτταροπενία, Αναιμία, Λευκοπενία, Θρομβοκυτταροπενία, θα σας δημιουργήσουν αρχικά πραγματικό "πονοκέφαλο", όμως ο/η Κτηνίατρός σας θα σας βοηθήσει να καταλάβετε τι ακριβώς συμβαίνει στο ζώο σας.
Έτσι λοιπόν, συχνές διαταραχές στην αιματολογική εικόνα του ζώου που νοσεί είναι:
α.Θρομβοκυτταροπενία (μείωση του αριθμού των αιμοπεταλίων).Εύρημα που μπορεί να εντοπισθεί τόσο στη χρόνια όσο και στην οξεία μορφή της νόσου, αλλά δεν θεωρείται σε καμία περίπτωση "ειδικό". Μπορεί δηλαδή να εμφανιστεί και σε άλλες παθολογικές καταστάσεις ή δηλητηριάσεις και γι'αυτό θα πρέπει να συνοδεύεται από ειδικές για την Ερλιχίωση εξετάσεις αίματος. Αντίθετα, η Θρομβοκυτταροπενία μπορεί και να μην εντοπισθεί σε ένα ζώο που έχει Ερλιχίωση. Το ότι τα αιμοπετάλια δηλαδή είναι φυσιολογικά σε μια εξέταση αίματος, ΔΕΝ ΑΠΟΚΛΕΙΕΙ ΤΗΝ ΠΙΘΑΝΟΤΗΤΑ ΤΟ ΖΩΟ ΝΑ ΝΟΣΕΙ ή απλά να είναι φορέας!!!
β.Αναιμία (μείωση του αριθμού των ερυθρών αιμασφαιρίων και του αιματοκρίτη). Αυτή μπορεί να είναι μέτρια στα αρχικά στάδια της νόσου ή βαριά και ΜΗ αναγεννητική στην χρόνια μορφή, όταν πια έχει προσβληθεί ο μυελός των οστών του ζώου.
γ.Λευκοπενία (μείωση του αριθμού των λευκών κυττάρων του αίματος) έως και σοβαρή Πανκυτταροπενία όταν πια έχει εγκατασταθεί η χρόνια μορφή της νόσου και έχει προκαλέσει καταστολή του μυελού των οστών (σε αυτά τα ζώα θα πρέπει να γίνεται και διαγνωστική διευρεύνηση για την πιθανότητα συνύπαρξης Λευχαιμίας!).
δ.Λεμφοκυττάρωση.
ΟΡΟΛΟΓΙΚΗ ΕΞΕΤΑΣΗ: αυτή είναι η εξέταση αίματος που ανιχνεύει αντισώματα κατά της Ερλιχίωσης και είναι η πιο διαδεδομένη και συχνή εξέταση που εφαρμόζεται στην κλινική πράξη για τη διάγνωση της ασθένειας στο σκύλο. Η εξέταση αυτή πρέπει να γίνεται περίπου 1 μήνα (το αργότερο) μετά την επιβεβαιωμένη μόλυνση του ζώου από τσιμπούρια ή κατά τη χειμερινή περίοδο προληπτικά σε όλα τα ζώα που διαβιούν ή επισκέπτονται ενδημικές περιοχές.
Η πραγματοποίηση της εξέτασης μερικές ημέρες μετά την ανεύρεση τσιμπουριού επάνω στο ζώο, μπορεί να δώσει ΨΕΥΔΩΣ αρνητικό αποτέλεσμα, διότι χρειάζεται ένα εύλογο χρονικό διάστημα ώσπου ο οργανισμός του ζώου να παράγει τα απαραίτητα αντισώματα. Δεν έχει επομένως κανένα νόημα ο πανικός και η πραγματοποίηση εξετάσεων αμέσως μετά το τσίμπημα από τσιμπούρι (με την προϋπόθεση πως το ζώο είναι κλινικά υγιές και δεν έχει εκδηλώσει κανένα σύμπτωμα αδιαθεσίας!!!) και σε καμία περίπτωση η χωρίς αποδείξεις προληπτική χορήγηση φαρμάκων. Το διάστημα του ενός μηνός είναι ασφαλές τόσο για την σωστή διάγνωση, όσο και για την αποφυγή προόδου της ασθένειας και επιδείνωσης της κατάστασης του ζώου. Βασική προϋπόθεση σε όλα αυτά είναι πως ο ιδιοκτήτης είναι ενημερωμένος και ζητά τη συμβουλή Κτηνιάτρου!
ΝΑ ΘΥΜΑΣΤΕ:
♦ Η άμεση εξέταση αίματος μετά την ανεύρεση ή πιο σωστά, μετά την προσκόλληση τσιμπουριού επάνω σε ένα σκύλο (πάντα υπάρχει η πιθανότητα το τσιμπούρι να ήταν εκεί πολύ πριν το δείτε!!!), μπορεί να οδηγήσει σε ΨΕΥΔΩΣ αρνητικό αποτέλεσμα.
♦ Ένας μήνας (3-4 εβδομάδες) είναι λογικό και ασφαλές χρονικό διάστημα προκειμένου να διαγνωσθεί η μόλυνση του ζώου από την Ερλίχια χωρίς να διακινδυνεύσουμε την εξέλιξή της. ΠΡΟΣΟΧΗ! αν μέσα στο χρονικό διάστημα του ενός μηνός το ζώο εμφανίσει ύποπτη κλινική εικόνα, τότε θα πρέπει να εξετάζεται άμεσα από Κτηνίατρο.
♦ Η επιτυχής και έγκαιρη διάγνωση είναι το αποτέλεσμα συνεργασίας μεταξύ ενός υπεύθυνου και ενημερωμένου ιδιοκτήτη και ενός έμπειρου και αφοσιωμένου Κτηνιάτρου.
♦ Η προληπτική χορήγηση φαρμάκων κατά της Ερλιχίωσης δεν συνιστάται σε περιστατικά που δεν έχουν επιβεβαιωθεί***
***Εδώ βέβαια ίσως να εξαιρούσα την περίπτωση όπου επάνω στο ζώο βρέθηκαν ΠΟΛΛΑ τσιμπούρια, τα οποία το πιο πιθανό να βρίσκονταν πάνω στο ζώο και να πολλαπλασιάζονταν για καιρό πριν ο ιδιοκτήτης τα αντιληφθεί! Δυστυχώς η πιθανότητα ένα ζώο που βρέθηκε να έχει πολλά τσιμπούρια επάνω του να μολύνθηκε από την Ερλίχια, είναι πολύ υψηλή! Σε αυτά τα ζώα θα δικαιολογούσα ενδεχομένως την προληπτική χορήγηση των κατάλληλων φαρμάκων, πάντοτε με συμβουλή Κτηνιάτρου και φυσικά τις συνοδές ειδικές εξετάσεις αίματος!!!! (ιδίως αν λάβει κανείς υπ'όψιν ότι η κλινική βελτίωση παρατηρείται μέσα σε 24-48ώρες από την έναρξη της κατάλληλης αγωγής)
Αν βρείτε τσιμπούρι επάνω στο ζώο σας και η πρώτη εξέταση αίματος μετά από ένα μήνα βγεί αρνητική, ζητήστε από τον κτηνίατρό σας να την επαναλάβει μετά από 2 ή 3 μήνες για να εξασφαλίσετε ένα πιο σίγουρο αποτέλεσμα. Ακόμα όμως και αν δεν έχετε βρει τσιμπούρια επάνω στο ζώο σας, θα ήταν καλό μετά την πάροδο της θερινής περιόδου (και ιδίως αν έχετε ταξιδέψει σε ενδημικές περιοχές), να κάνετε προληπτικά την εξέταση αυτή εφόσον στατιστικά πλέον, το ποσοστό μόλυνσης των σκύλων από Ερλιχίωση είναι ιδιαίτερα υψηλό!
Η ορολογική εξέταση μπορεί να γίνει είτε στο ιατρείο με ένα "γρήγορο" τεστ το οποίο δίνει απλά μια ΘΕΤΙΚΗ ή ΑΡΝΗΤΙΚΗ απάντηση, είτε σε ειδικό εργαστήριο που μας δίνει ακριβή τίτλο αντισωμάτων.
Αλήθεια είναι πως ΔΕΝ αρρωσταίνουν όλοι οι σκύλοι που βρίσκονται θετικοί στην ορολογική εξέταση της Ερλιχίωσης. Η παρουσία αντισωμάτων κατά της νόσου δηλαδή, δεν σημαίνει απαραίτητα πως το ζώο είναι άρρωστο. Μπορεί απλά να σημαίνει "ΠΡΟΗΓΟΥΜΕΝΗ" έκθεση του ζώου στη νόσο, όπου ο ίδιος ο οργανισμός του ζώου την αντιμετώπισε. Η σοβαρότητα της ασθένειας όμως είναι τέτοια, που επιβάλλει τη χορήγηση αγωγής σε κάθε ζώο που βρίσκεται θετικό για πρώτη φορά είτε έχει, είτε δεν έχει ακόμα εκδηλώσει τα συμπτώματα της νόσου.
ΣΗΜΑΝΤΙΚΗ ΣΗΜΕΙΩΣΗ:
!!!Περιπτώσεις όπου η ορολογική εξέταση του ζώου ήταν αρνητική για την Ερλιχίωση, παρά την συμβατή κλινική εικόνα και τις συμβατές συνοδές αιματολογικές εξετάσεις έχουν παρατηρηθεί στην κλινική πράξη. Τα περιστατικά αυτά συνήθως οφείλονται σε στελέχη της Ehrlichia, διαφορετικά από την Ehrlichia canis ή σε διαφορετικά είδη της ίδιας οικογένειας με την Ehrlichia ( πχ, Ehrlichia ewingii, Anaplasma platys, Babesia canis κα.)!!! Αυτές είναι και οι πιο δύσκολες περιπτώσεις στην κλινική πράξη τόσο από διαγνωστικής απόψεως, εφόσον προϋποθέτουν την πραγματοποίηση πολλών και ειδικών εξετάσεων αίματος, όσο και από την άποψη της επικοινωνίας με τον ιδιοκτήτη του ζώου ο οποίος μην παίρνοντας μια τελική και σίγουρη απάντηση ως προς το αίτιο της αδιαθεσίας του ζώου του, συχνά χάνει την εμπιστοσύνη του στον Κτηνίατρο.
ΝΑ ΘΥΜΑΣΤΕ: τα τσιμπούρια μπορεί να μεταδώσουν στο ζώο σας διαφορετικά είδη βακτηρίων που ανήκουν στην ίδια οικογένεια με την Ehrlichia. Οι ορολογικές εξετάσεις συνήθως ανιχνεύουν αντισώματα κατά του συχνότερου είδους- Ε.canis-ή και μερικών ακόμα. Αν ο Κτηνίατρός σας έχει όλα τα απαραίτητα εκείνα στοιχεία που συνηγορούν υπέρ της προσβολής του ζώου σας από την "ΑΣΘΕΝΕΙΑ ΤΟΥ ΤΣΙΜΠΟΥΡΙΟΥ", θα πρέπει να τον εμπιστευθείτε και να ακολουθήσετε τις οδηγίες και συμβουλές του!
Μια ακόμα πιο ειδική εξέταση που επιτρέπει την ανίχνευση του DNA της Ehrlichia καθώς και την ταυτοποίηση του είδους που προσέβαλλε το ζώο, είναι η PCR. Η εξέταση αυτή γίνεται σε εξειδικευμένα εργαστήρια και συνήθως προτιμάται σε περιπτώσεις όπου επιθυμείται η ταχεία διάγνωση της νόσου όταν ακόμα βρίσκεται στην οξεία φάση.
Να θυμάστε:
Η διάγνωση της Ερλιχίωσης μπορεί να γίνει ΤΥΧΑΙΑ, κατά τη διαγνωστική διερεύνηση ενός ζώου που υποφέρει ταυτόχρονα από άλλα παθολογικά αίτια! Σε αυτά τα περιστατικά, η θεραπευτική αγωγή μπορεί να απαιτεί το συνδυασμό πολλών και διαφορετικών φαρμάκων, όχι απαραίτητα ειδικών για την Ερλιχίωση.
Πολλοί ιδιοκτήτες ζητούν να γίνει άμεσα, μετά την ολοκλήρωση της θεραπείας του ζώου τους, επανάληψη της ορολογικής εξέτασης ( τίτλου αντισωμάτων ). Αυτή είναι μία τακτική που ΔΕΝ εφαρμόζουμε στο ιατρείο μας, για τον εξής λόγο: Δεν έχει νόημα η άμεση επανεξέταση του ζώου για τον τίτλο αντισωμάτων, διότι πολύ απλά απαιτείται ένα χρονικό διάστημα από 6 έως 9 μήνες ώσπου ο τίτλος αντισωμάτων να "πέσει". Πολλοί σκύλοι που έχουν θεραπευθεί από τη νόσο, εξακολουθούν να έχουν υψηλό τίτλο αντισωμάτων για πολλούς μήνες έως και χρόνια!
Η παρακολούθηση της αποτελεσματικότητας της θεραπευτικής αγωγής γίνεται με επαναληπτικές "ΓΕΝΙΚΕΣ" εξετάσεις αίματος με τις οποίες ελέγχονται ο αιματοκρίτης, ο αριθμός των αιμοπεταλίων, ο αριθμός των λευκών αιμοσφαιρίων. Η βελτίωση αυτών των παραμέτρων και φυσικά και της κλινικής εικόνας του ζώου επιβεβαιώνουν την επιτυχία της θεραπείας.
Σπανιότερα,οι αιματολογικές διαταραχές (όπως η Θρομβοκυτταροπενία), θα επιμείνουν για μεγάλο χρονικό διάστημα μετά την ολοκλήρωση της θεραπευτικής αγωγής αποκαρδιώνοντας κυριολεκτικά τον ιδιοκτήτη που έχοντας καταβάλει μεγάλη προσπάθεια για τη θεραπεία του ζώου του, δεν βλέπει τα πολυπόθητα "φυσιολογικά" αποτελέσματα στην γενική εξέταση αίματος του ζώου του. Είναι ακόμα άγνωστο το γιατί κάποια ζώα που υποβάλλονται σε θεραπευτική αγωγή κατά της Ερλιχίωσης και ενώ έχουν επανέλθει σε πλήρως φυσιολογική κλινική εικόνα, εξακολουθούν να έχουν σοβαρές ανωμαλίες στην γενική εξέταση αίματος (χαμηλό αιματοκρίτη, χαμηλά αιμοπετάλια κα.). Η ταυτόχρονη προσβολή του ζώου από άλλα παθολογικά αίτια (πχ. ΛΕΪΣΜΑΝΙΩΣΗ) είναι από τα βασικότερα αίτια που θα πρέπει να διερευνηθούν, μαζί με την πιθανότητα η νόσος της Ερλιχίωσης να έχει περάσει στη ΧΡΟΝΙΑ φάση της στο συγκεκριμένο ζώο. Άλλα αίτια όπως η διαταραχή του ανοσοποιητικού συστήματος του ζώου από την Ερλίχια είναι επίσης πιθανά.
ΒΙΟΧΗΜΙΚΕΣ ΕΞΕΤΑΣΕΙΣ: στις εξετάσεις αυτές συχνά ευρήματα είναι η αύξηση των ηπατικών ενζύμων (ALT, ALP ) που συχνά οδηγεί σε εσφαλμένο συμπέρασμα ηπατικής νόσου στα ζώα που δεν ελέγθηκαν μέσω ορολογικής εξέτασης για Ερλιχίωση!
Ένα ακόμα διαγνωστικό "όπλο" στη διάθεσή μας για τη διάγνωση της Ερλιχίωσης, είναι μια πολύ ειδική εργαστηριακή εξέταση που ονομάζεται PCR! Η εξέταση αυτή βοηθάει στον εντοπισμό του είδους της Ehrlichia που έχει προσβάλλει το συγκεκριμένο ζώο, αλλά η μεγαλύτερη διαγνωστική της αξία έγκειται στην δυνατότητα που προσφέρει στον έλεγχο της αποτελεσματικότητας της θεραπευτικής αγωγής.
-ΘΕΡΑΠΕΥΕΤΑΙ Η ΕΡΛΙΧΙΩΣΗ ΤΟΥ ΣΚΥΛΟΥ?
ΝΑΙ!
Η θεραπεία της Ερλιχίωσης είναι εφικτή, με την προϋπόθεση ότι η διάγνωση γίνει έγκαιρα και ΠΡΙΝ προκληθεί καταστολή του μυελού των οστών.
Η θεραπεία συνίσταται στη χορήγηση ειδικών φαρμάκων καθώς και υποστηρικτικής αγωγής, ανάλογα με την κλινική εικόνα του ζώου.
Το φάρμακο εκλογής είναι η Δοξυκυκλίνη (Κτηνιατρικό σκεύασμα: Ronaxan, Ανθρώπινο σκεύασμα: Vibramycin) που χορηγείται με την μορφή χαπιών από το στόμα και η συστηνόμενη διάρκεια της θεραπείας φθάνει τις 28 ημέρες!
Κλινική βελτίωση στα ζώα που διαγνώσθηκαν έγκαιρα (οξεία ή αρχή χρόνιας φάσης ) παρατηρείται πολύ σύντομα, έως και 24-48 ώρες μετά την έναρξη της αγωγής!
ΣΕ ΚΑΜΙΑ ΠΕΡΙΠΤΩΣΗ ΑΥΤΟ ΔΕΝ ΣΗΜΑΙΝΕΙ ΠΩΣ Η ΑΓΩΓΗ ΘΑ ΠΡΕΠΕΙ ΝΑ ΔΙΑΚΟΠΤΕΤΑΙ ΟΤΑΝ ΤΟ ΖΩΟ ΒΕΛΤΙΩΝΕΤΑΙ ΚΛΙΝΙΚΑ!
Στην περίπτωση πρόωρης διακοπής της θεραπείας, το ζώο θα υποτροπιάσει σύντομα!
Εκτός από την Δοξυκυκλίνη, στη διάθεσή μας για την αντιμετώπιση της νόσου υπάρχει και μια ακόμα δραστική ουσία: η Ιμιδοκάρβη (Κτηνιατρικό σκεύασμα: Imizol). Η ουσία αυτή ανήκει στην κατηγορία των αντιπρωτοζωϊκών φαρμάκων και χορηγείται μέσω υποδόριας ένεσης από ΚΤΗΝΙΑΤΡΟ! Το φάρμακο αυτό έχει μακρά διάρκεια δράσης στο σώμα του ζώου και καλό ποσοστό επιτυχίας στην καταπολέμηση της E.canis, όταν χορηγείται ΣΕ ΣΥΝΔΥΑΣΜΟ ΜΕ ΤΗΝ ΑΠΟ ΤΟΥ ΣΤΟΜΑΤΟΣ ΘΕΡΑΠΕΥΤΙΚΗ ΑΓΩΓΗ!
Η κλινική κατάσταση του ζώου που νοσεί από Ερλιχίωση είναι αυτή που θα καθορίσει το είδος και την διάρκεια της αγωγής καθώς και την συμπλήρωσή της από άλλες θεραπευτικές μεθόδους. Η αντιμετώπιση της ΧΡΟΝΙΑΣ μορφής Ερλιχίωσης είναι πραγματική πρόκληση για τον κλινικό Κτηνίατρο, εφόσον η απλή χορήγηση αντιβιοτικών ΔΕΝ είναι αρκετή. Η ΜΕΤΑΓΓΙΣΗ αίματος είναι συχνά υποχρεωτική σε ζώα που νοσούν από την βαριά χρόνια μορφή της νόσου και έχουν εκδηλώσει σοβαρή αναιμία λόγω καταστολής του μυελού των οστών. Η αναγέννηση του μυελού σε ζώα που καταφέρουν να επιβιώσουν της ΧΡΟΝΙΑΣ φάσης, μπορεί να διαρκέσει έως και 120 ημέρες μετά την έναρξη αγωγής.
Η χρήση γλυκοκορτικοειδών (κορτιζόνης ) είναι επίσης αποδεκτή σε ορισμένα περιστατικά Ερλιχίωσης στα οποία είτε γιατί η αιματολογική και κλινική εικόνα του ζώου δεν μπορεί αρχικά να διαχωριστεί από την Αυτοάνοση Θρομβοκυτταροπενία, είτε γιατί η αιμορραγίες απειλούν άμεσα τη ζωή του ζώου, είτε γιατί η ίδια η Ερλιχίωση έχει προκαλέσει παθολογικές καταστάσεις που ανταποκρίνονται στην χορήγηση κορτιζόνης (πχ. πολυαρθρίτιδα, αγγειίτιδα, μηνιγγίτιδα).
ΣΕ ΑΥΤΗ ΤΗΝ ΙΣΤΟΣΕΛΙΔΑ ΔΕΝ ΘΑ ΒΡΕΙΤΕ ΔΟΣΟΛΟΓΙΕΣ ΚΑΙ ΠΡΟΤΑΣΕΙΣ ΘΕΡΑΠΕΥΤΙΚΩΝ ΣΧΗΜΑΤΩΝ. Η ΧΟΡΗΓΗΣΗ ΤΩΝ ΦΑΡΜΑΚΩΝ ΑΥΤΩΝ ΘΑ ΠΡΕΠΕΙ ΝΑ ΓΙΝΕΤΑΙ ΣΕ ΕΠΙΒΕΒΑΙΩΜΕΝΑ ΠΕΡΙΣΤΑΤΙΚΑ ΚΑΙ ΥΠΟ ΤΗΝ ΑΥΣΤΗΡΗ ΕΠΙΒΛΕΨΗ ΚΤΗΝΙΑΤΡΟΥ. Η ΔΟΣΟΛΟΓΙΑ ΚΑΘΩΣ ΚΑΙ Η ΔΙΑΡΚΕΙΑ ΤΗΣ ΘΕΡΑΠΕΙΑΣ ΕΞΑΡΤΑΤΑΙ ΑΠΟ ΤΗΝ ΚΛΙΝΙΚΗ ΕΙΚΟΝΑ ΤΟΥ ΖΩΟΥ ΚΑΙ ΥΠΟΛΟΓΙΖΕΤΑΙ ΜΕ ΒΑΣΗ ΤΟ ΣΩΜΑΤΙΚΟ ΒΑΡΟΣ ΤΟΥ ΖΩΟΥ.
-ΠΑΡΑΚΟΛΟΥΘΗΣΗ ΤΗΣ ΑΓΩΓΗΣ!
Η παρακολούθηση της θεραπείας του ζώου από τη στιγμή που ξεκινήσει, είναι απολύτως απαραίτητη διότι σε πολλές περιπτώσεις η νόσος μπορεί να επιμείνει για μεγάλο χρονικό διάστημα παρά την χορήγηση όλων των απαραίτητων φαρμάκων.
Η πραγματοποίηση γενικής εξέτασης αίματος μέσα στις πρώτες 10-15 ημέρες από την έναρξη της θεραπείας είναι απαραίτητη. Από τις πρώτες αιματολογικές ενδείξεις πως το ζώο ανταποκρίνεται στην θεραπεία, είναι η άνοδος του αριθμού των αιμοπεταλίων. Η εξέταση αυτή πρέπει να επαναλαμβάνεται σε 1 έως και 3 μήνες μετά το τέλος της θεραπείας, διότι υπάρχει πάντα ο κίνδυνος αναζωπύρωσης της νόσου.
Αυτό που είναι δύσκολο να αποδειχθεί μετά τη λήξη της θεραπευτικής αγωγής, είναι πως ο υπεύθυνος μικροοργανισμός απομακρύνθηκε από το σώμα του ζώου.
Η σύντομη επανάληψη της ορολογικής εξέτασης για τον τίτλο αντισωμάτων δεν έχει κανένα νόημα να γίνεται, διότι το χρονικό διάστημα που απαιτείται για την πτώση των αντισωμάτων δεν ακολουθεί την πορεία της κλινικής βελτίωσης του ζώου. Δηλαδή, ένα ζώο που έχει ιαθεί κλινικά και που οι αιματολογικές εξετάσεις του επανέρχονται στα φυσιολογικά επίπεδα, μπορεί ακόμα να έχει υψηλό τίτλο αντισωμάτων για αρκετό χρονικό διάστημα μετά το τέλος της θεραπείας.
Ας μην ξεχνάμε δε, την πιθανότητα επαναμόλυνσης ενός ζώου που ζει ή ταξιδεύει σε ενδημικές περιοχές (εκεί δηλαδή που η νόσος είναι συχνή)!!!
Συμπερασματικά!
Η πρόγνωση της Ερλιχίωσης για τα ζώα στα οποία θα γίνει έγκαιρη διάγνωση και θεραπεία είναι καλή. Πιο σωστά, η ΒΡΑΧΥΠΡΟΘΕΣΜΗ πρόγνωση είναι καλή.
♦Τι σημαίνει ΒΡΑΧΥΠΡΟΘΕΣΜΗ πρόγνωση?
Σημαίνει πως το ζώο μπορεί να εκδηλώσει εντυπωσιακή και ταχύτατη κλινική βελτίωση ακόμα και μέσα στις πρώτες 24-48 ώρες μετά την έναρξη της κατάλληλης αγωγής. Αυτό ισχύει για τα ζώα εκείνα που διαγνώσθηκαν κατά την οξεία ή μέτριας σοβαρότητας χρόνια μορφή της Ερλιχίωσης. Για τα ζώα όμως που διαγνώσθηκαν σε προχωρημένα στάδια της χρόνιας μορφής της νόσου και κατάφεραν να ανακάμψουν κλινικά, μπορεί να απαιτηθεί χρονικό διάστημα πολλών μηνών (έως και έτους), μέχρι να διαπιστωθεί η πλήρης αιματολογική τους ανάκαμψη. Μέχρι δηλαδή οι εξετάσεις αίματος να επανέλθουν στα φυσιολογικά τους επίπεδα.
Η ΜΑΚΡΟΠΡΟΘΕΣΜΗ πρόγνωση της νόσου εξαρτάται από πολλούς παράγοντες με πρώτιστο όπως ήδη αναφέραμε την έγκαιρη διάγνωσή της. Άλλοι παράγοντες όμως, εξίσου σημαντικοί είναι η έγκαιρη διάγνωση και αντιμετώπιση παθολογικών καταστάσεων που μπορεί να συνυπάρχουν με τη νόσο της Ερλιχίωσης στον ίδιο οργανισμό.
Κατά τη γνώμη μου, κάθε ζώο που διαγιγνώσκεται με τη νόσο της Ερλιχίωσης, θα πρέπει να ελέγχεται και για τη νόσο της ΛΕΪΣΜΑΝΙΩΣΗΣ!!! Η ταυτόχρονη παρουσία και των δύο νοσημάτων στο ίδιο ζώο είναι κάτι που πολύ συχνά συναντάμε στην κλινική πράξη.
Από την κλινική μου εμπειρία είναι πως τελικά τα ζώα που θα καταλήξουν από τη νόσο της Ελιχίωσης είναι είτε αυτά στα οποία η διάγνωση έγινε εξαιρετικά καθυστερημένα και στις περισσότερες από αυτές τις περιπτώσεις ο θάνατος προήλθε κυρίως από τις ανεξέλεγκτες αιμορραγίες που προκάλεσε η ασθένεια, είτε ζώα στα οποία συνυπήρχαν άλλες εξίσου σοβαρές ασθένειες (κυρίως η Λεϊσμανίωση) και μη έχοντας διαγνωσθεί έγκαιρα εκδηλώθηκαν με την σοβαρότερη μορφή τους συμβάλλοντας έτσι στην περαιτέρω αποδυνάμωση του ανοσοποιητικού συστήματος του ζώου.
-ΠΡΟΛΑΜΒΑΝΕΤΑΙ Η ΕΡΛΙΧΙΩΣΗ?
Πρόληψη είναι να ελέγχουμε το ζώο μας τακτικά για την παρουσία εξωπαρασίτων επάνω του, να πραγματοποιούμε τακτικούς αιματολογικούς ελέγχους τουλάχιστον μία φορά το χρόνο, να ρωτάμε τον Κτηνίατρό μας για ό,τι απορίες έχουμε και να μη βασιζόμαστε σε αυτά που μας λένε οι φίλοι μας σχετικά με την ασθένεια .
Εμβόλιο κατά της νόσου της Ερλιχίωσης, έως και σήμερα ( 2016 ) ΔΕΝ υπάρχει. Η πρόληψη βασίζεται αποκλειστικά στην κατά το δυνατό αποφυγή τσιμπημάτων από τσιμπούρια, τόσο μέσω σωστής και τακτικής χρήσης εξωπαρασιτοκτόνων όσο και αποφυγής έκθεσης των ζώων μας σε περιβάλλοντα με υψηλό παρασιτικό φορτίο (χωράφια και αγροί που δεν έχουν ψεκαστεί με εξωπαρασιτοκτόνα, συγχρωτισμός με αδέσποτα ζώα, συνωστιμός ζώων σε ξενώνες ή εκτροφεία όπου δεν τηρούνται βασικοί κανόνες υγιεινής κα).
Η προληπτική χρήση αντιβιοτικών σε ζώα που είτε βρέθηκαν να έχουν τσιμπούρια επάνω τους είτε εκτέθηκαν σε ύποπτα περιβάλλοντα, αναφέρεται συχνά ως εφαρμοζόμενη τακτική ιδίως σε χώρους όπως εκτροφεία, ξενώνες, άσυλα προστασίας αδέσποτων.
Η προσωπική μου άποψη είναι πως η αλόγιστη χρήση αντιβιοτικών είτε από τους ιδιοκτήτες είτε από τους Κτηνιάτρους, είναι κατάχρηση και σύντομα θα οδηγήσει σε αδιέξοδο με την ανάπτυξη ανθεκτικότητας των μικροοργανισμών στα φάρμακα. Η χρήση αντιβιοτικών θα πρέπει να γίνεται μόνον σε επιβεβαιωμένα περιστατικά Ερλιχίωσης και υπό την επίβλεψη Κτηνιάτρου. Η προληπτική χορήγηση αντιβιοτικών μπορεί να αποτελέσει μια αποδεκτή προσέγγιση στις περιπτώσεις εκείνες όπου τα μέτρα καταπολέμησης των τσιμπουριών δεν επαρκούν (εκτροφεία, άσυλα περισυλλογής αδέσποτων ζώων και γενικά χώροι όπου συνωστίζονται πολλά ζώα). Σε αυτές τις περιπτώσεις, όπου η παρουσία τσιμπουριών είναι έντονη και η μόλυνση από Ερλίχια πολύ πιθανή, η προλητπική χορήγηση ειδικών αντιβιοτιών υπό την επίβλεψη Κτηνιάτρου είναι αποδεκτή.
Ο καλύτερος τρόπος πρόληψης της ασθένειας αυτής (ή καλύτερα, πρόληψης της δυσμενούς εξέλιξης της ασθένειας αυτής) είναι ο τακτικός αιματολογικός έλεγχος του ζώου σας, τουλάχιστον μία φορά το χρόνο κατά τη χειμερινή περίοδο, όπως και η ΑΜΕΣΗ εξέταση του ζώου από Κτηνίατρο σε περίπτωση που βρεθεί επάνω του τσιμπούρι. Η συμβουλή αυτή αφορά τόσο στα ζώα που διαβιούν, όσο και σε αυτά που επισκέπτονται ενδημικές περιοχές.
ΝΑ ΘΥΜΑΣΤΕ:
Η ΙΑΣΗ ΤΟΥ ΖΩΟΥ ΑΠΟ ΤΗΝ ΕΡΛΙΧΙΩΣΗ ΔΕΝ ΣΥΝΟΔΕΥΤΑΙ ΑΠΟ ΕΦ'ΟΡΟΥ ΖΩΗΣ ΑΝΟΣΙΑ. Το ζώο που νόσησε δηλαδή και θεραπεύθηκε, ΔΕΝ ΠΡΟΣΤΑΤΕΥΤΑΙ στον μέλλον από ΑΝΤΙΣΩΜΑΤΑ κατά της Ερλιχίωσης. Το ίδιο ζώο μπορεί να μολυνθεί ξανά και ξανά αν τσιμπηθεί από μολυσμένα τσιμπούρια.
Ο ρόλος της χυμικής ανοσίας (αντισώματα) είναι μηδαμινός στην αντιμετώπιση της νόσου από τον οργανισμό του ζώου. Τον κύριο ρόλο στην ασθένεια αυτή (όπως και στην Λεϊσμανίωση), έχει η Κυτταρική ανοσία.
Μην βγάζετε συμπεράσματα μόνοι σας για την μικρής διάρκειας αδιαθεσία του ζώου σας αποδίδοντάς την στην καλοκαιρινή ζέστη! Κάθε ζώο που εκδηλώνει έστω και 1 ή 2 ημέρες αδιαθεσίας, θα πρέπει να εξετάζεται από Κτηνίατρο!
ΝΑ ΘΥΜΑΣΤΕ:
♦Για να μεταφέρει το τσιμπούρι τη νόσο σε ένα σκύλο, θα πρέπει πρώτα να μολυνθεί το ίδιο από άλλο μολυσμένο σκύλο. Το ίδιο το τσιμπούρι δηλαδή δεν μεταφέρει τη νόσο στους απογόνους του (δεν γεννάει τσιμπούρια με τον μικροοργανισμό της Ερλιχίωσης). Αν λοιπόν έχετε περισσότερους από έναν σκύλους και η νόσος διαγνωσθεί σε έναν, φροντίστε να πραγματοποιήσετε τις κατάλληλες εξετάσεις και στα υπόλοιπα ζώα σας άμεσα.
♦Αφήνετε τα ζώα σας για φιλοξενία σε καθαρούς χώρους όπου τηρούνται αυστηρά μέτρα υγιεινής και καθαριότητας και κάνετε προληπτικά αγωγή κατά των εξωπαρασίτων πριν το ζώο σας εισαχθεί σε ένα τέτοιο χώρο!
♦Σήμερα υπάρχουν στη διάθεσή μας διάφορα ασφαλή σκευάσματα κατά των εξωπαρασίτων όπως σπρέυ, αμπούλες, χάπια. Ζητήστε τη συμβουλή του Κτηνιάτρου σας για την επιλογή του καταλληλότερου σκευάσματος και μην εμπιστεύεστε φθηνά σκευάσματα που κυκλοφορούν στο εμπόριο και υπόσχονται καταπολέμηση παντός είδους εξωπαρασίτου!!!!
ΜΗΝ ΧΟΡΗΓΕΙΤΕ ΣΤΑ ΖΩΑ ΣΑΣ ΑΝΤΙΒΙΟΤΙΚΑ ΥΠΟ ΤΙΣ ΥΠΟΔΕΙΞΕΙΣ ΦΙΛΩΝ ΚΑΙ ΓΝΩΣΤΩΝ ΠΟΥ ΕΤΥΧΕ ΝΑ ΕΧΟΥΝ ΖΩΟ ΜΕ ΕΡΛΙΧΙΩΣΗ!
ΣΕ ΚΑΜΙΑ ΠΕΡΙΠΤΩΣΗ ΔΕΝ ΠΡΕΠΕΙ ΝΑ ΧΟΡΗΓΟΥΜΕ ΤΑ ΦΑΡΜΑΚΑ ΚΑΤΑ ΤΗΣ ΕΡΛΙΧΙΩΣΗΣ ΠΡΟΛΗΠΤΙΚΑ, ΧΩΡΙΣ ΤΗ ΣΥΜΒΟΥΛΗ ΚΤΗΝΙΑΤΡΟΥ, ΣΕ ΖΩΑ ΠΟΥ ΔΕΝ ΕΧΕΙ ΔΙΑΓΝΩΣΘΕΙ ΟΤΙ ΠΑΣΧΟΥΝ ΑΠΟ ΤΗ ΝΟΣΟ ΕΠΕΙΔΗ ΒΡΗΚΑΜΕ ΕΝΑ ΤΣΙΜΠΟΥΡΙ ΕΠΑΝΩ ΤΟΥΣ Ή ΕΧΟΥΜΕ ΔΕΥΤΕΡΟ ΖΩΟ ΤΟ ΟΠΟΙΟ ΝΟΣΕΙ Ή ΕΠΕΙΔΗ ΤΟ ΖΩΟ ΤΟΥ ΓΕΙΤΟΝΑ ΜΑΣ ΝΟΣΕΙ!
-ΠΟΙΟΙ ΟΙ ΚΙΝΔΥΝΟΙ ΓΙΑ ΤΟΝ ΑΝΘΡΩΠΟ ΑΠΟ ΤΗΝ ΕΡΛΙΧΙΩΣΗ?
Τα περισσότερα είδη της Ehrlichia μπορούν να μολύνουν τον άνθρωπο. Ο σκύλος όμως, δεν ευθύνεται για την άμεση μετάδοση της νόσου αυτής στον άνθρωπο.
ΣΕ ΚΑΜΙΑ ΠΕΡΙΠΤΩΣΗ Η ΣΥΝΥΠΑΡΞΗ ΜΑΣ ΜΕ ΕΝΑ ΖΩΟ ΠΟΥ ΝΟΣΕΙ ΑΠΟ ΕΡΛΙΧΙΩΣΗ Ή Η ΦΡΟΝΤΙΔΑ ΤΟΥ, ΔΕΝ ΑΠΟΤΕΛΕΙ ΚΙΝΔΥΝΟ ΜΟΛΥΝΣΗΣ ΜΑΣ ΑΠΟ ΤΗ ΝΟΣΟ!
Η Ερλιχίωση του ανθρώπου προκαλείται από διαφορετικά είδη του γένους Ehrlichia( E.chaffeensis,Ehrlichia ewingii,Ehrlichia muris-like) ικανά να προκαλέσουν σοβαρά κλινικά συμπτώματα μηνιγγοεγκεφαλίτιδας, οξείας νεφρικής ανεπάρκειας, οξείας αναπνευστικής ανεπάρκειας. Κάποια από αυτά τα είδη μπορεί να προσβάλλουν και το σκύλο και τον άνθρωπο.
Η μετάδοση της νόσου στον άνθρωπο γίνεται (όπως και στον σκύλο ) από τσίμπημα μολυσμένου τσιμπουριού. Υπάρχουν διαφορετικά είδη τσιμπουριών που παρασιτούν στα ζώα και στον άνθρωπο ανά τον κόσμο αλλά και πολλές διαφορετικές ασθένειες που μπορεί να μεταδοθούν από αυτά στον άνθρωπο. Σε συγκεκριμένες περιοχές του πλανήτη ο κίνδυνος μετάδοσης στον άνθρωπο ασθενειών από τα τσιμπούρια είναι ιδιαίτερα υψηλός και γι'αυτό το λόγο δίνονται ιδιαίτερες ταξιδιωτικές οδηγίες σε όσους μετακινούνται προς αυτές τις περιοχές. (βρείτε χρήσιμες συμβουλές ΕΔΩ.)
Η μετάδοση της νόσου ΔΕΝ μπορεί να γίνει από το σκύλο στον άνθρωπο. Ο ρόλος του σκύλου βέβαια στη μεταφορά τσιμπουριών είναι πρωταρχικής σημασίας για την απ'ευθείας μετάδοση της νόσου από το τσιμπούρι στον άνθρωπο.
Εκεί που ο σκύλος μας "κόλλησε" τσιμπούρια, θα μπορούσαμε να τσιμπηθούμε και εμείς!
Ο χειρισμός τσιμπουριών κατά την μηχανική αφαίρεσή τους από το σκύλο αποτελεί έναν πιθανό κίνδυνο μετάδοσης της νόσου στον άνθρωπο.
ΔΕΝ ΑΦΑΙΡΟΥΜΕ ΤΑ ΤΣΙΜΠΟΥΡΙΑ ΑΠΟ ΤΟ ΣΩΜΑ ΤΟΥ ΣΚΥΛΟΥ ΜΑΣ ΜΕ ΓΥΜΝΑ ΧΕΡΙΑ!!!
Στην ανθρώπινη ιατρική το ενδιαφέρον έχει στραφεί και στη μελέτη της πιθανής μετάδοσης της νόσου από άνθρωπο σε άνθρωπο κατά την μετάγγιση μολυσμένου αίματος.
ΒΙΒΛΙΟΓΡΑΦΙΑ
1.Greene: Infectious Diseases of the dog and cat.
2.Dwight D. Bowman: Georgis' Parasitology for veterinarians.
3.http://www.cvbd.org/en/tick-borne-diseases/ehrlichiosis/pathogenesis-and-transmission/
4.http://www.cdc.gov/ehrlichiosis/
6.Treatment of Canine Ehrlichiosis: World small animal veterinary association, world congress proceedings, 2011. Edward B. Breitschwerdt, DVM, DACVIM.
7. A.Rick Alleman, DVM, PhD, DACVP, DABVP (Canine and Feline Practice), CEO and Manager of Lighthouse Veterinary Consultants, Alachea, FL, USA: More Than Just E. canis: The Increasingly complicated story of Ehrlichiosis. ABVP 2015.
8.ST.J.ETTINGER, ED.C.FELDMAN: Textbook of Veterinary Internal Medicine. pp 632-634:CANINE EHRLICHIOSIS.
9.www.cvbd.org (2010): Canine Ehrlichiosis-from Acute Infection to Chronic Disease, CVBD DIGEST World Forum,No 7.
